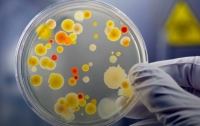
Первый случай дифтерии в 2018 году не подтвержден лабораторно, - МОЗ

ВСЕ НОВОСТИ
-
 21:48 Здоровье
21:48 Здоровье
Из-за коронавируса могут вспыхнуть эпидемии других болезней, - мнение
-
 20:35 Здоровье
20:35 Здоровье
В Украине зафиксировали 21 случай заболевания дифтерией
-
 19:54 Здоровье
19:54 Здоровье
Второй случай дифтерии зафиксировали на Харьковщине
-
 23:23 Здоровье
23:23 Здоровье
Врачи рассказали о ситуации с дифтерией
-
 11:09 Здоровье
11:09 Здоровье
Врачи бьют тревогу: ожидается большая эпидемия дифтерии
-
 18:45 Здоровье
18:45 Здоровье
Врачи предупредили о возможной вспышке дифтерии
-
 08:12 Здоровье
08:12 Здоровье
На Закарпатье зафиксировали вспышку дифтерии
-
 23:23 Здоровье
23:23 Здоровье
Дифтерия добралась до киевских школ
-
 15:05 Здоровье
15:05 Здоровье
От дифтерии и столбняка: в Украине запускают кампанию вакцинации взрослых
-
 16:50 Здоровье
16:50 Здоровье
Украинцам угрожает еще одна опасная инфекция
-
 11:02 Происшествия
11:02 Происшествия
Два новых случая дифтерии зафиксированы в Запорожской области
-
 18:51 Здоровье
18:51 Здоровье
Украиной стремительно распространяется опасная болезнь
-
 14:32 Здоровье
14:32 Здоровье
В Украине зафиксирован четвертый случай опасного заболевания
-
 07:47 Здоровье
07:47 Здоровье
Дифтерия в Украине: количество заболевших растет
-
22:48 Здоровье
22:48 Здоровье
Первый случай дифтерии в 2018 году не подтвержден лабораторно, - МОЗ




